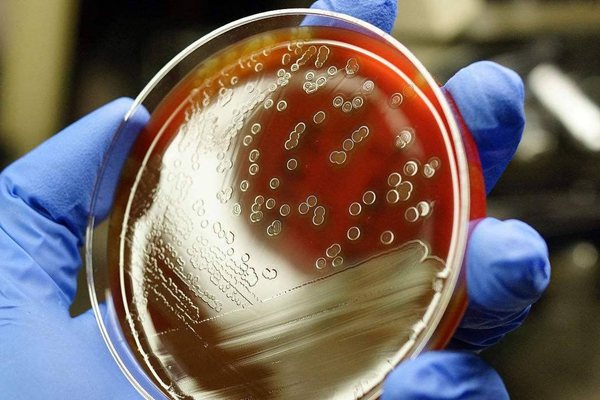
為什么注射青霉素前要做皮試,青霉素皮試過敏怎么辦

當(dāng)我們生病需要注射青霉素的時候,一般都是打兩針,一針是皮試,皮試后才真正注射青霉素,為什么注射青霉素前要做皮試?如果青霉素皮試過敏該怎么辦呢?下面就來為您揭曉答案。![]() 青霉菌是什么? 在弄清注射青霉素前要做皮試的原因前要弄清青霉菌是什么? 青霉素是抗菌素的一種,是指分子中含有青霉烷、能破壞細(xì)菌的細(xì)胞壁并在細(xì)菌細(xì)胞的繁殖期起殺菌作用的一類抗生素,是由青霉菌中提煉出的抗生素。青霉素是很常用的抗菌藥品。但每次使用前必須做皮試,以防過敏。青霉素是一種高效、低毒、臨床應(yīng)用廣泛的重要抗生素。它的研制成功大大增強(qiáng)了人類抵抗細(xì)菌性感染的能力,帶動了抗生素家族的誕生。 ![]() 為什么注射青霉素前要做皮試? 什么是“皮試”呢?皮試就是皮膚(皮內(nèi)),敏感性的一種試驗(yàn)的簡稱。由于青霉素有較強(qiáng)的過敏反應(yīng),如不作皮試或皮試結(jié)果判斷錯誤,注射青霉素可引發(fā)過敏反應(yīng),嚴(yán)重的可致過敏性休克而死亡,所以一般在注射青霉素時都要做“皮試”。 ![]() 為什么注射青霉素很疼? 1、青霉素有刺激性。青霉素鉀中含有鉀離子,刺激性較大,容易引起疼痛,打青霉素只能打在屁股上。 2、溫度影響。氣溫低時,青霉素水溶性會變得更差,而寒冷刺激會引起局部肌肉收縮,增加肌內(nèi)注射的阻力,同時也增加了局部藥物的濃度,那么就會影響注射的速度,從而增加針頭阻塞幾率,導(dǎo)致屁股疼痛加重。所以,一般打青霉素之前,都會通過恒溫箱臨時加熱藥液再進(jìn)行注射,這樣有助于緩解屁股的疼痛。 ![]() 青霉素皮試過敏怎么辦? 一般青霉素過敏表現(xiàn)在皮試以后,皮試位置出現(xiàn)的紅圈,以及紅斑這樣的情況。在排除“假陽性”的情況下,也不用過于焦慮,您可以采取頭孢和阿莫西林這些的方法來進(jìn)行治療,如果您堅(jiān)決要使用青霉素的話,你可以選擇“脫敏注射”,即分多次、每次小劑量注射。 ![]() 青霉素皮試出現(xiàn)“假陽性”的常見原因 1、皮內(nèi)注射操作不規(guī)范(如針頭較粗較鈍或注射過深對皮膚刺激大、注入藥量過多、皮試液放置過久等)。 2、消毒液對皮膚的刺激(未待其干燥就行皮內(nèi)注射,陽性結(jié)果其實(shí)是被試者對消毒液過敏)。 3、結(jié)果判斷掌握不夠科學(xué)(只要皮丘發(fā)紅或病人有不適主訴時不予分析,怕?lián)L(fēng)險判斷為陽性)。 4、缺乏對照手段(患者或家屬不愿接受生理鹽水對照試驗(yàn),缺乏排除假陽性的科學(xué)依據(jù))。 ![]() 打了青霉素喝酒怎么辦? 注射青霉素后是禁止飲酒的,因?yàn)楹染茣黾痈闻K的負(fù)擔(dān),就會有副作用出現(xiàn),影響青霉素的效果,但是很多人喝酒喝到一半才想起來自己打了青霉素,那該怎么辦呢? 第一,要看時間。青霉素注射在體內(nèi)2-3小時,它會隨尿排出!如果是注射青霉素三四天后飲酒,不會有太大影響的。 第二,看飲酒量。如果是少量飲酒,不會影響腎臟和肝臟正常工作,也是沒有太大問題的。 第三,看身體反應(yīng)。如果身體有明顯反應(yīng),必須要第一時間就醫(yī),如果沒有明顯反應(yīng),可以實(shí)時觀測,一旦出現(xiàn)癥狀及時就醫(yī)。 ![]() 除了青霉素,還有哪些藥物需要皮試? 頭孢菌素類:頭孢菌素類的過敏反應(yīng)較青霉素少得多,但靜注和口服頭孢菌素均可發(fā)生過敏反應(yīng),目前對頭孢菌素應(yīng)用前是否需要進(jìn)行皮試試驗(yàn)?zāi)壳吧杏袪幾h。也有人很疑惑如果青霉素陽性,能否選擇頭孢菌素類藥物。 鏈霉素:鏈霉素為一種氨基糖苷類抗生素,、鏈霉素的過敏性休克的發(fā)生率低于青霉素,但死亡率較高。 破傷風(fēng)抗毒素:破傷風(fēng)抗毒素可在注射中或注射后數(shù)分鐘至數(shù)十分鐘內(nèi)突然發(fā)生過敏性休克,如不及時搶救可迅速死亡。 鹽酸普魯卡因:鹽酸普魯卡因是短效酯類局麻藥,其起效慢,持續(xù)時間短和具有潛在的過敏性。 門冬酰胺酶:本藥是從大腸桿菌中提取的酶制劑類抗腫瘤藥,用藥后 5%——20% 的患者可出現(xiàn)過敏癥狀,皮試后如有紅斑或風(fēng)團(tuán)則為陽性反應(yīng)。 胸腺肽注射液:胸腺肽為胸腺激素的一種,陽性反應(yīng)者禁用。 降鈣素:降鈣素是甲狀腺濾泡旁細(xì)胞分泌的激素,易發(fā)生過敏反應(yīng),陽性者最好不要使用本藥。 維生素 B1:本藥較少采用注射用藥,且不宜采用靜脈注射。肌內(nèi)注射前應(yīng)稀釋后做皮試。 ![]() 為什么歐美國家注射青霉素不用做皮試? 為什么我國注射青霉素一定要做皮試,歐美國家卻不用?,其主要原因是國產(chǎn)的青霉素和歐美的青霉素在提純度上有差別,所謂的青霉素過敏,并不是青霉素本身,而是青霉素生產(chǎn)和存儲過程中產(chǎn)生的雜質(zhì)惹的禍! 這些雜質(zhì)中,主要有一種成分叫青霉噻唑分子。如果這種雜質(zhì)含量多,就非常容易讓很多人產(chǎn)生過敏反應(yīng)。據(jù)一項(xiàng)統(tǒng)計(jì)顯示,我國通用的青霉素,一支價格6-7元。而歐美國家青霉素的價格,相當(dāng)于30-40元人民幣一支。而在歐美國家,高純度的青霉素所導(dǎo)致的過敏率只有0.004%-0.015%。 那這種情況,再給每個打青霉素的人,做皮試反而劃不來了。這也就是為什么歐美國家注射青霉素不用做皮試的原因了。 |